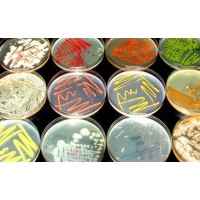
Microbiology Microbiology

Important!
Please call us if you would like to purchase face masks or hand sanitiser
+64 9 421 0368
Mediscope International Ltd is 100% New Zealand owned company with a focus on the healthcare and scientific sectors within the Oceania region facilitating procurement and distribution of leading brands and products.
Our Product Categories
Featured Products
Invisorb Spin Universal Kit
Options 50 or 250 Purifications OverviewThe InvisorbĀ® Spin Universal Kit simplifies isolation of nucleic acids from a variety of starting materials such as blood, cell-free body fluids, s..
Novel Coronavirus Strain 2019-nCoV
Product FeaturesExceptional value for moneyRapid detection of 2019-nCoVPositive copy number standard curve for quantificationHighly specific detection profileHigh priming efficiencyBroad dynamic detection range (>6 logs)Sensitive to < 100 ..
MA CAR Air Purifier
FGSFGThe MA-CAR air purifier is one of the only car purifiers with HEPA H13 filtration to capture airborne toxins so small, you can't even see them. It's suited for cars, trucks, and SUVs up to 7 seats. Quietly removes 99.9% of harmful toxins includi..
MA40 Air Purifier
The bestselling MA-40 blends style and technology for long-term air cleaning. Ideal for large rooms in homes, apartments, offices, schools, universities, classrooms, hospitals, restaurants, and other businesses. Trusted to remove 99.9% of harmful par..